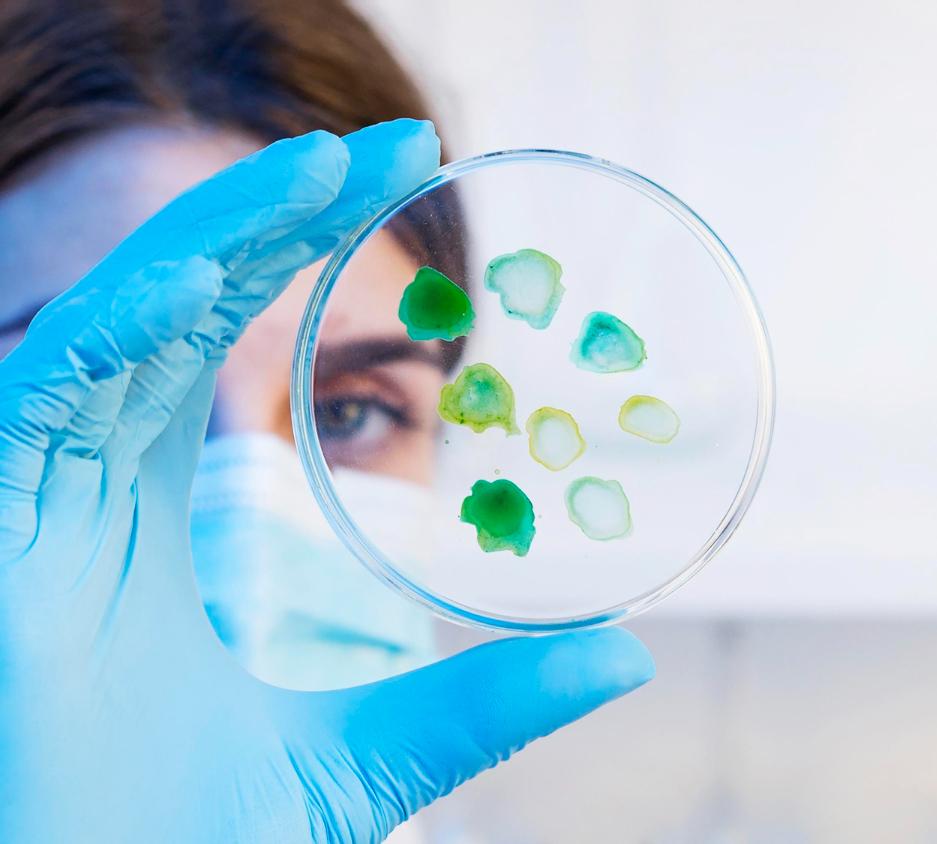
СПРС-терапия

СПРС-терапия


Что такое фибробласты?
Фибробласты — солдаты нашей кожи! Одни из самых красивых клеток in vitro. Их строение безупречно, тела натренированы. Они гибки, как гимнасты. В клеточной культуре они распластаны по поверхности — дну культурного пластика и образуют причудливые «морозные узоры», которые без труда отметит опытный глаз. Это их фирменный стиль!
А как изумительно красивы отдельные колонии—клоны фибробластов, если их редко «разбросать» (посеять с низкой клональной плотностью) на чашке Петри. Каждая клетка делится и может давать потомство — сотни, тысячи себе подобных. Эти колонии похожи на стройные закрученные косяки рыб, которые иногда плотно и разнонаправленно сливаясь, образуют правильные, совершенные и поразительные по своей красоте звёздчатые структуры!
Функции фибробластов многообразны! Они организуют, обновляют и восстанавливают дом, в котором живут. Кажа человека содержит по меньшей мере три различные субпопуляции фибробластов, занимающие уникальные клеточные ниши: фибробласты папиллярного, ретикулярного слоёв дермы и ассоциированные с волосяными фолликулами. Они создают своё микроокружение. Здесь все знают друг друга в лицо и ведут себя по законам этого пространства.
Фибробласты происходят из стволовых клеток мезенхимного происхождения. Эти превращения описывает фибробластический дифферон. Дифферон — это строгая клеточная иерархия, от стволовой клетки через клетку-предшественника к фибробласту и далее к фиброциту. Фибробласты — долгоживущие клетки и даже превращаясь в конечную форму своего развития — фиброциты — они по-прежнему прекрасны!
И каждый раз дух захватывает, когда садишься за любимый Цейссовский микроскоп, наводишь резкость на объектив и видишь это медленно наплывающее чудо-природы…
Алла Зорина, к.м.н. ПАО ИСКЧ

Инволюционные изменения кожи
Интересный факт: исследование J. Varani (2006г.) показало, что в коже человека старше 50-ти лет фибробластов почти на 35% меньше, чем в коже 25-летнего, а по данным G. Fisher (2002г.) количество коллагена снижено на 75%. В результате, кожа человека старше 50-ти лет теряет былую плотность, истончается и становится менее упругой и эластичной, количество морщин увеличивается, они становятся более глубокими и заметными.
Что же такое СПРС-терапия?


Оценка эффективности метода проводилась Институтом стволовых клеток человека (ИСКЧ), и результаты пациентов, участвовавших в исследовании (мужчины и женщины от 40 до 65 лет) показали выраженное улучшение качества кожи, а именно увеличилась плотность, восстановилась упругость и эластичность, цвет кожи стал однородным и здоровым.

Как часто следует проводить СПРС-терапию?

Регенераторный потенциал. Паспорт кожи
Паспорт кожи помогает получить ответы на многие важные вопросы:
- Какой регенераторный потенциал вашей кожи?
- Как быстро можно ожидать результат после проведения той или иной косметологической процедуры;
- Какие должны быть оптимальные параметры применения различных аппаратных методов восстановления кожи;
- С какого возраста можно рекомендовать инвазивные и неинвазивные вмешательства по эстетическим показаниям;
- Как часто можно проводить СПРС-терапию с целью сохранения молодости и здоровья кожи.

В чём универсальность СПРС-терапии?
Преимущества СПРС-терапии:

Этапы операции
Перед процедурой
2. Забор биоптата кожи (из заушной области забирается маленький образец кожи);
Процедура
4. Определяется регенераторный потенциал и формируется паспорт кожи;
5. Планируется наиболее эффективная СПРС-программа, с рекомендациями по количеству и периодичности СПРС-терапии и совместимости с иными косметологическими методиками.
6. Изготовление СПРС-препарата. В соответствии с запатентованной методикой в течение 40-55 дней в лабораторных условиях фибробласты культивируются и наращиваются до необходимого количества. Отбираются и стимулируются только те клетки, которые показывают наиболее значительную способность к воспроизводству важнейших для дермы компонентов;
7. Создание банка фибробластов и их криоконсервирование. Клетки закладывается в персональный для каждого пациента криобанк на срок от 10 лет и более;
8. СПРС-терапия: с помощью специальных медицинских игл методом тунельной техники препарат вводится в кожу. Продолжительность процедуры составляет 40 — 60 минут;
После процедуры
Клинические результаты

После проведения СПРС-терапии можно рассчитывать на следующие биологические и клинические эффекты:

Биологические эффекты
- Увеличение активных фибробластов в коже;
- Стимуляция активности фибробластов;
- Значительное увеличение коллагена в дерме;
Клинические эффекты
- Восстановление микроструктуры кожи;
- Увеличение толщины и плотности кожного покрова;
- Нормализованный гидробаланс кожи;
- Торможение процессов старения;
- Уменьшение количества и глубины морщин, эффективное противостояние к появлению новых;
- Восстановление здорового цвета кожи и самых важных характеристик дермы.


Отзывы
оставить отзывстоимость
частые вопросы
УСИЛИТЬ РЕЗУЛЬТАТ ПОМОЖЕТ






















